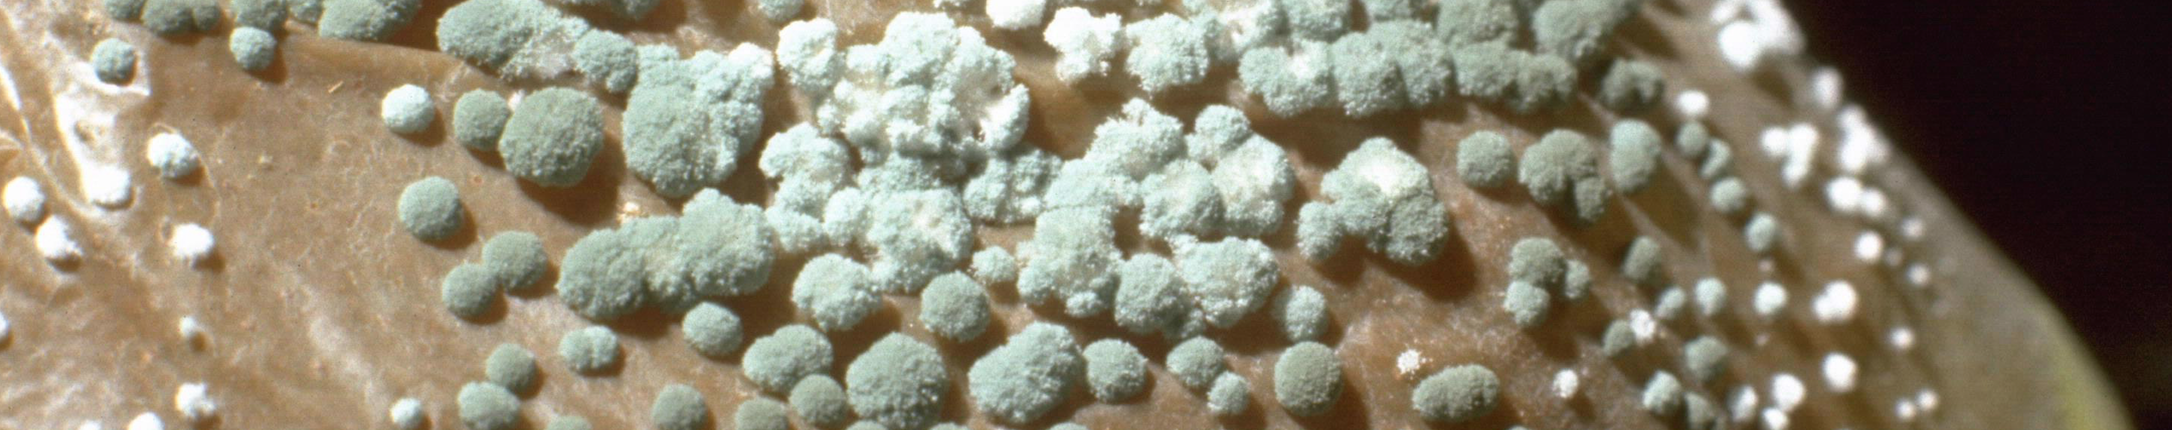
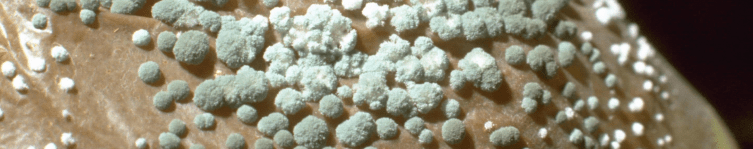
Schermafbeelding 2015-05-16 om 20.35.01

I always knew it. Pancakes with maple syrup are so good, they must be “healthy”.
Canadian researchers took a different look at North American maple tree syrup. They published that the phenolic compounds contained in the syrup potentiates antimicrobial susceptibility by increasing outer-membrane permeability and effectively inhibit efflux pump activity, in addition to reducing biofilm formation.
After all the research into the antimicrobial activity of foods & spices (e.g. garlic), I am happy to see a less smelly product being promoted. In addition, this may explain why antimicrobial resistance is low in the Netherlands, a country with a proud tradition of pancake restaurants everywhere.
Seriously, antimicrobial activities have been reported from many extracts of “food & spices”, but none really made it into clinical practice. So far the mushrooms seem to be winning. Go Penicillium.
Photo: wikipedia
Discover more from Reflections on Infection Prevention and Control
Subscribe to get the latest posts sent to your email.

Maple syrup, honey, red wine and the list goes on. There are useful compounds out there that can help in our fight against disease-causing microbes, but they need rigorous assessment. There always seems to be a new headline about this sort of thing, so it’s useful to delve into the details with this and other options like this: http://www.senseaboutscience.org/blog.php/89/antimicrobial-surfaces-derived-from-tea-wine-and-chocolate-promising-but-a-long-way-off
LikeLike